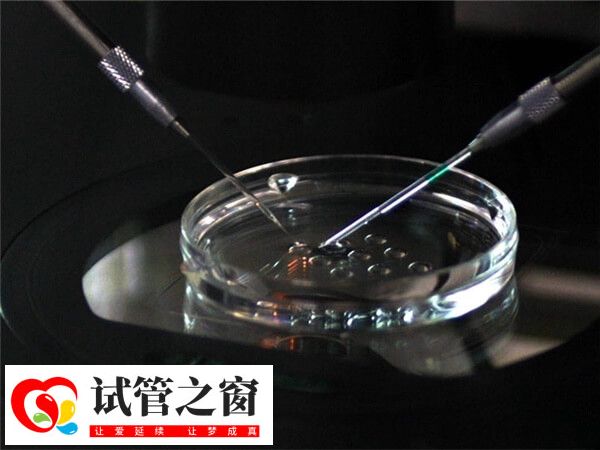
高齡適合做第三代試管嬰兒

41歲高齡女性做第三代試管嬰兒好嗎?
41歲生第一胎是可以做三代試管的,不過41歲屬于是高齡孕婦,一般這個年紀通過做第三代試管的話可以很好的避免胎兒出現異常的情況,從而可以孕育出一個健康的小寶寶。第三代試管嬰兒也被稱為植入前基因診斷。體外受精-胚胎移植(IVF-ET)也稱為體外受精和胚胎移植,指從夫妻雙方取出卵子和精子,完成體外受精。形成胚胎然后移植到子宮腔的過程。可以篩選健康胚胎,防止遺傳病傳播的輔助生殖技術。
第三代試管嬰兒適合人群
目前,比較先進的檢測方法是運用基因芯片技術,對胚胎的46條染色體進行全面篩查,從而挑選出染色體數目和結構正常的胚胎移植,運用此項檢測,可以提高患者的臨床妊娠率,降低早期流產風險,降低出生缺陷。
- 1. 年齡大于35歲的患者;
- 2. 自然流產≧3次,排除子宮或內分泌因素;
- 3. 生育過染色體異常疾病患兒的夫婦;
- 4. 3次以上移植未孕者,包括新鮮及冷凍移植;
- 5. 染色體數目及結構異常的夫婦,如羅氏易位,部分克氏綜合癥等。
所以說像41歲這個年紀是可以做第三代試管的,可以避免出現胎兒出現異常。在第三代試管嬰兒還未出現的時候,試管嬰兒技術無法幫助患有特殊遺傳性疾病的患者達到優生優育的目的,直到第三代試管技術的誕生。





